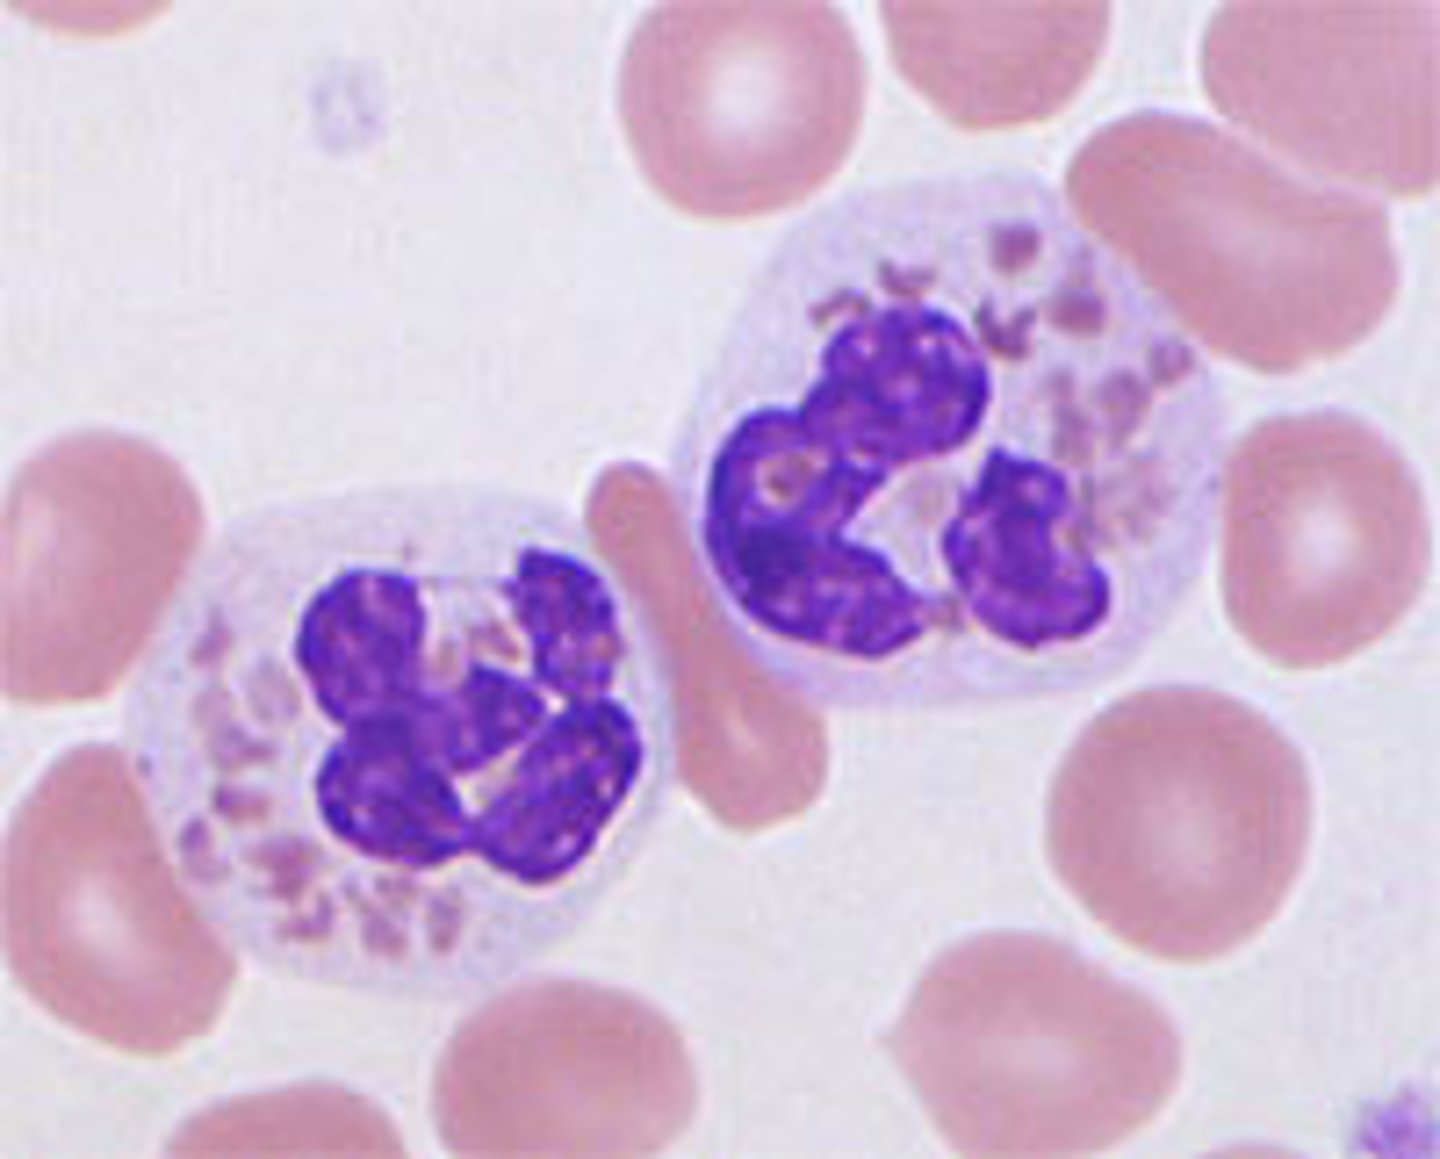
<p>infection</p>

Vistas Capítulo 10 Vocabulario
1/93
There's no tags or description
Looks like no tags are added yet.
Name | Mastery | Learn | Test | Matching | Spaced |
|---|
No study sessions yet.
94 Terms
la boca
mouth

el brazo
arm

la cabeza
head

el corazón
heart

el cuello
neck

el cuerpo
body

el dedo
finger

el dedo del pie
toe

el estómago
stomach

la garganta
throat

el hueso
bone

la nariz
nose

el oído
(sense of) hearing; inner ear

el ojo
eye

la oreja
(outer) ear

el pie
foot

la pierna
leg

la rodilla
knee

el tobillo
ankle

el accidente
accident

el antibiótico
antibiotic

la aspirina
aspirin

la clínica
clinic

el consultorio
doctor's office

el/la dentista
dentist

el/la doctor(a)
doctor

el dolor (de cabeza)
(head) ache; pain

el enfermero/a
nurse

el examen médico
physical exam

la farmacia
pharmacy

la gripe
flu

el hospital
hospital

la infección
infection
el medicamento
medication

la medicina
medicine

la operación
operation

el/la paciente
patient

la pastilla
pill

la radiografía
X-ray

recetar
to prescribe

la receta
prescription

el resfriado
cold (illness)

la sala de emergencia (s)
emergency room

la salud
health

el síntoma
symptom

la tos
cough

caerse
to fall (down)

dañar
to damage; to break down

darse con
to bump into; to run into

doler
to hurt

enfermarse
to get sick

estar enfermo/a
to be sick

estornudar
to sneeze

lastimarse (el pie)
to injure (one's foot)

olvidar
to forget

poner una inyección
to give an injection

prohibir
to prohibit

romper
to break

romperse (la pierna)
to break (one's leg)

sacar(se) un diente
to have a tooth removed

ser alérgico/a (a)
to be allergic (to)

sufrir una enfermedad
to suffer an illness

tener dolor
to have a pain

tener fiebre
to have a fever

tomar la temperatura
to take someone's temperature

torcerse (el tobillo)
to sprain (one's ankle)

toser
to cough

congestionado/a
congested

embarazada
pregnant

grave
grave; serious

mareado/a
dizzy; nauseated

médico/a
medical

saludable
healthy

sano/a
healthy

a menudo
often

a tiempo
on time

a veces
sometimes
además (de)
furthermore; besides

apenas
hardly; scarcely

así
like this; so
bastante
enough; rather
casi
almost

con frecuencia
frequently
de niño/a
as a child

de vez en cuando
from time to time
despacio
slowly

menos
less

mientras
while

muchas veces
a lot; many times
poco
little

por lo menos
at least
pronto
soon
rápido
quickly

todos los días
every day
